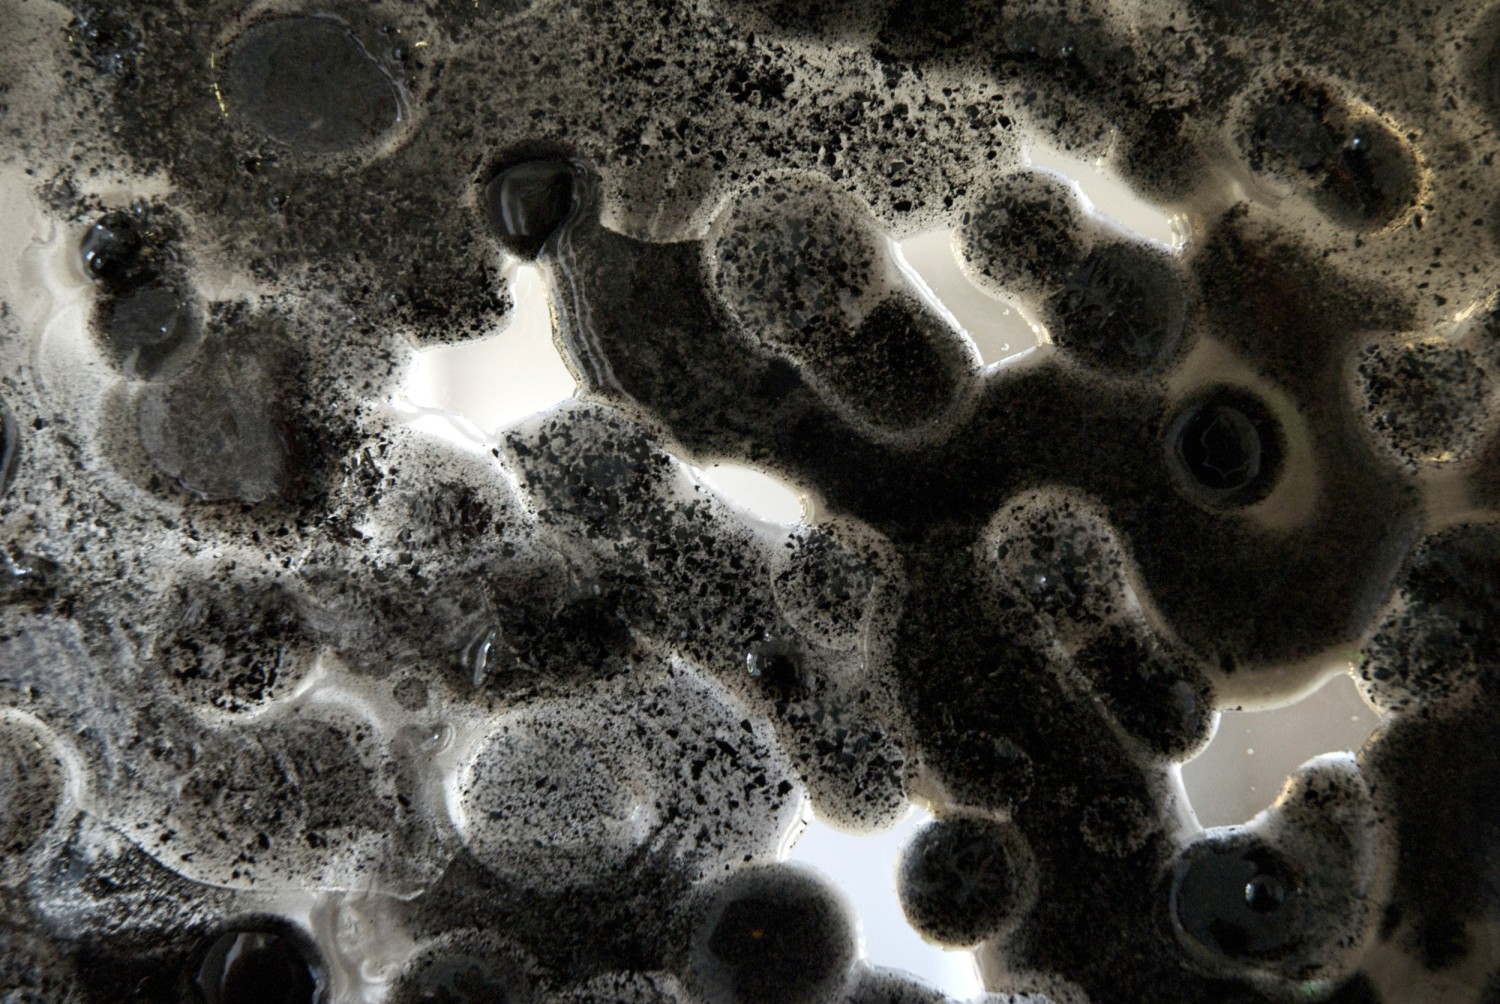
st-eloy-detail-noir-photo-emmanuel-barrois.jpg

La transmission est une valeur cardinale dans le secteur de l’artisanat d’art, qu’elle s’opère en famille ou non. Elle est garante de la pérennité des métiers mais aussi des liens entre les artisanes et les artisans, de génération en génération. La succession de mutations sociales et technologiques questionne ce patrimoine culturel que constituent les métiers d’art mais aussi la façon même de les exercer. À l’heure où 52 % des 18-24 ans se rêvent en chef(fe)s d’entreprises* (mais de quel métier ? quel secteur d’activité ? sans importance ?), celles et ceux qui détiennent l’admirable maîtrise de savoir sublimer la matière ont aussi la responsabilité de renouveler l’exercice de la gouvernance des entreprises.
Emmanuel Barrois a obtenu le titre de Maître d’art en 2010, et interrogé sur la pérennité de son métier, il affirme : « La transmission dans l’artisanat d’art est probablement ce qui fait la différence avec le milieu de l’art. Comprendre que, dans l’artisanat, nous sommes un maillon d’une chaîne, c’est comprendre que nous ne sommes que des passeurs. »
Raphaël Barrois, même s’il a reçu en héritage cette relation particulière au verre, a préféré s’émanciper de l’atelier familial pour développer ses propres créations. Il assume le besoin d’exister par lui-même, la volonté d’« ouvrir [sa] propre boîte et d’exprimer [sa] créativité, de [se] challenger en partant de zéro, avoir [sa] propre manière de faire ». L’intention est forte ; dans les faits, Raphaël bénéficie des 2 000 m² et des outils des Ateliers Barrois dédiés à des projets ultra pointus dans le secteur architectural, ainsi que de l’expertise de son père.
Les métiers d’art, comme d’autres secteurs, se confrontent à l’émancipation de jeunes artisanes et artisans qui veulent affirmer leur singularité et fuir la hiérarchie, l’injonction à rentrer dans le moule et le rang. Emmanuel Barrois le reconnaît : « Les mentalités ont changé et les jeunes sont plus indépendants et plus libres. Le respect induit par la famille ou par le rapport hiérarchique se délite ; c’est une mutation sociale. »
De toute évidence, la nouvelle génération, qui a parfois du mal à dessiner la frontière entre abnégation et soumission, se désole d’une gestion humaine « à la dure ». En outre, l’artiste-verrière lauréate de la Fondation Culture & Diversité, Laurine Claude, définit le rapport entre le patron et le salarié comme asymétrique. Elle insiste : « Les expériences en entreprise sont parfois déplorables et c’est même ce qui pousse des jeunes à changer de voie. » C’est sans compter sur la misogynie persistante que de nombreuses professionnelles des métiers du verre dénoncent.
Malgré ces rapports humains difficiles, l’artisanat d’art ne se choisit pas par hasard et encore moins par opportunisme économique. Tous parlent d’une rencontre voire d’une reconnaissance et d’un mode de vie. Claire Pégis et Victor Stokowski, ayant respectivement fondé leur atelier, évoquent tour à tour la confiance qui leur a été accordée au moment de leur apprentissage. Victor parle avec gratitude du verrier qu’il a suivi outre-Manche pour se former : « Il est la première personne à m’avoir considéré comme un adulte ».
Le modèle traditionnel qui consistait
à embaucher et à diriger des compagnons exécutants et des ouvriers qualifiés aura probablement du mal à perdurer si les responsables d’ateliers n’actualisent pas leurs manières d’impliquer et de valoriser leurs équipes.
Laisser les vitraillistes donner une direction artistique différente de celle des peintres ou des maîtres verriers, « ce n’est pas l’usage », fait remarquer la créatrice de l’atelier La Couleur du Verre, Marie Grillo. Elle regrette que l’atelier soit toujours l’empreinte de son dirigeant et, sa production, la retranscription de son identité, « sauf à laisser s’exprimer le talent artistique et le geste créatif de son équipe ».
Claire Pégis aussi affirme que la personnalité du créateur est tellement centrale qu’il est difficile de reprendre l’entreprise ou, bien avant cela, de prendre des responsabilités. Victor Stokowski reconnaît qu’il a eu « de la chance » car ses modèles lui ont offert de nombreuses opportunités de s’entraîner au soufflage alors qu’il était apprenti, plutôt que de le cantonner aux activités d’assistant. Évidemment, les frais de fonctionnement d’un atelier de verrerie laissent peu de place à l’erreur et nécessitent de la discipline, mais laisser davantage de champ à l’expression des sensibilités et des compétences individuelles favoriserait le renouvellement
des entreprises et de leur production.
Que les chefs d’entreprises se rassurent, il existe des artisans qui ne se rêvent pas entrepreneurs et il en existerait même plus s’ils étaient mieux gratifiés et reconnus dans l’entreprise comme le souligne Quentin Ybert, collaborateur de Thibaut Nussbaumer qui a fondé TiPii Atelier à Toulouse.
Il y a une différence entre monter sa structure par défaut et le faire par conviction de proposer quelque chose de différent. Le duo de l’Atelier Horizon Verre, formé par Mélanie Gracia et Justin Hemery, le reconnaît : « C’est peut-être égoïste mais, quitte à galérer, autant que ce soit pour notre pomme ! ». Comme beaucoup de jeunes verriers français, ils ont fréquenté le centre de formation Espace VERRE au Québec pour avoir accès à une plus large diversité de techniques (pâte de verre, chalumeau, néon, peinture, vitrail et soufflage). À leur retour en France et après sept années de formation pour Justin, ils ont estimé qu’ils détenaient suffisamment de connaissances sur leur matière de prédilection pour monter leur propre entreprise. Le fonctionnement des ateliers leur aurait imposé de réaliser les dessins des autres s’ils avaient été salariés ; alors ils se sont dit « on n’a qu’à essayer et on verra bien ».
La précarité économique de leur structure laisse, pour l’instant, peu de place pour se demander si et comment ils transmettront, mais ils le souhaitent.
Emmanuel Barrois et Bruno de Pirey, qui ont tous les deux créé des ateliers d’envergure et ont acquis une renommée internationale, maintiennent l’envie de transmettre leurs entreprises et, pourquoi pas, à leurs salariés. Par précaution, Bruno de Pirey s’est associé avec un atelier de vitrail allemand, Peters, à Paderborn, tout en maintenant le sien installé dans le Berry depuis six ans et en projetant de se redévelopper à l’étranger prochainement. Son objectif n’est pas de spéculer sur la valeur de l’atelier, mais d’en assurer la pérennité dans le prolongement de la trajectoire qu’il a souhaité impulser.
D’autres créateurs choisissent de rester à une petite échelle en mettant en œuvre des coopérations avec des confrères et consœurs, comme une nouvelle manière de faire circuler les expertises et les gestes. C’est le cas d’Alice Lebourg, une des rares souffleuses de verre en France, qui varie entre son statut d’artiste-auteur et celui de salariée. Elle préfère venir en soutien à d’autres ateliers ou, comme Laurine Claude avec la designer textile Loumi Le Floc’h, imaginer des projets en co-développement. De son côté, peu après son entrée dans la vie professionnelle, Thibaut Nussbaumer a souhaité concrétiser sa vision d’un atelier générateur de rencontres et plus ouvert sur son environnement local. Il a également participé à la constitution de la Fédération des Artisans d’Art de Toulouse (FAAT) pour favoriser les conditions de synergie entre créateurs.
Parmi tous ceux-là, ils sont nombreux à avoir subi les méthodes managériales de structures prédominantes peu enclines à laisser de la place à l’exploration de la matière et de soi, encore moins aux initiatives personnelles. Et parce qu’ils ont parfois une assurance assumée, une autonomie et un talent exacerbés, les apprentis n’ont pas d’autres choix que de s’affranchir et de créer une structure dans laquelle ils mettent en place les conditions d’accueil qu’ils n’ont pas trouvées durant leur formation : transparence, gratitude, délégation… Si ces aptitudes managériales ne sont pas innées, encore faut-il qu’ils les aient acquises. Mais dans un secteur et une économie où l’entreprise unipersonnelle est encouragée, la stratégie d’implication des équipes semble bien négligée parmi les compétences suggérées.
Dans le plan national pour les métiers d’art annoncé cette année, des moyens supplémentaires ont été promis pour la formation des artisans. La maîtrise de la promotion digitale et de l’expansion internationale y semble prioritaire pour assurer la pérennité des savoir-faire. Mais si l’éclatement des petites unités de production réduit, de fait, l’embauche et l’opportunité d’apprendre à animer des équipes, les moyens et les énergies risquent de se diluer. Cela constitue un risque majeur pour la survie de certains métiers. Certains se réjouiront de la création de nouveaux métiers, avec de nouveaux matériaux et de nouveaux outils. Reste que le lien assuré par la transmission du geste entre pairs est insuffisamment protégé. Il existe de nombreuses initiatives d’archivage numérique des gestes (le projet [G]host, du Cerfav, le répertoire numérique du geste artisanal, l’exposition interactive du Cnam « Le savoir verre – Capturing Craft » en 2021, etc.). Ce n’est peut-être pas dans l’air du temps, mais il semble encore relativement souhaitable de soutenir un secteur dans lequel les individus se transmettent des savoirs, des savoir-être et des savoir-faire pour, entre autres, « faire société ».
— *Opinionway pour Go Entrepreneurs – La création d’entreprise en 2023 – Mars 2023